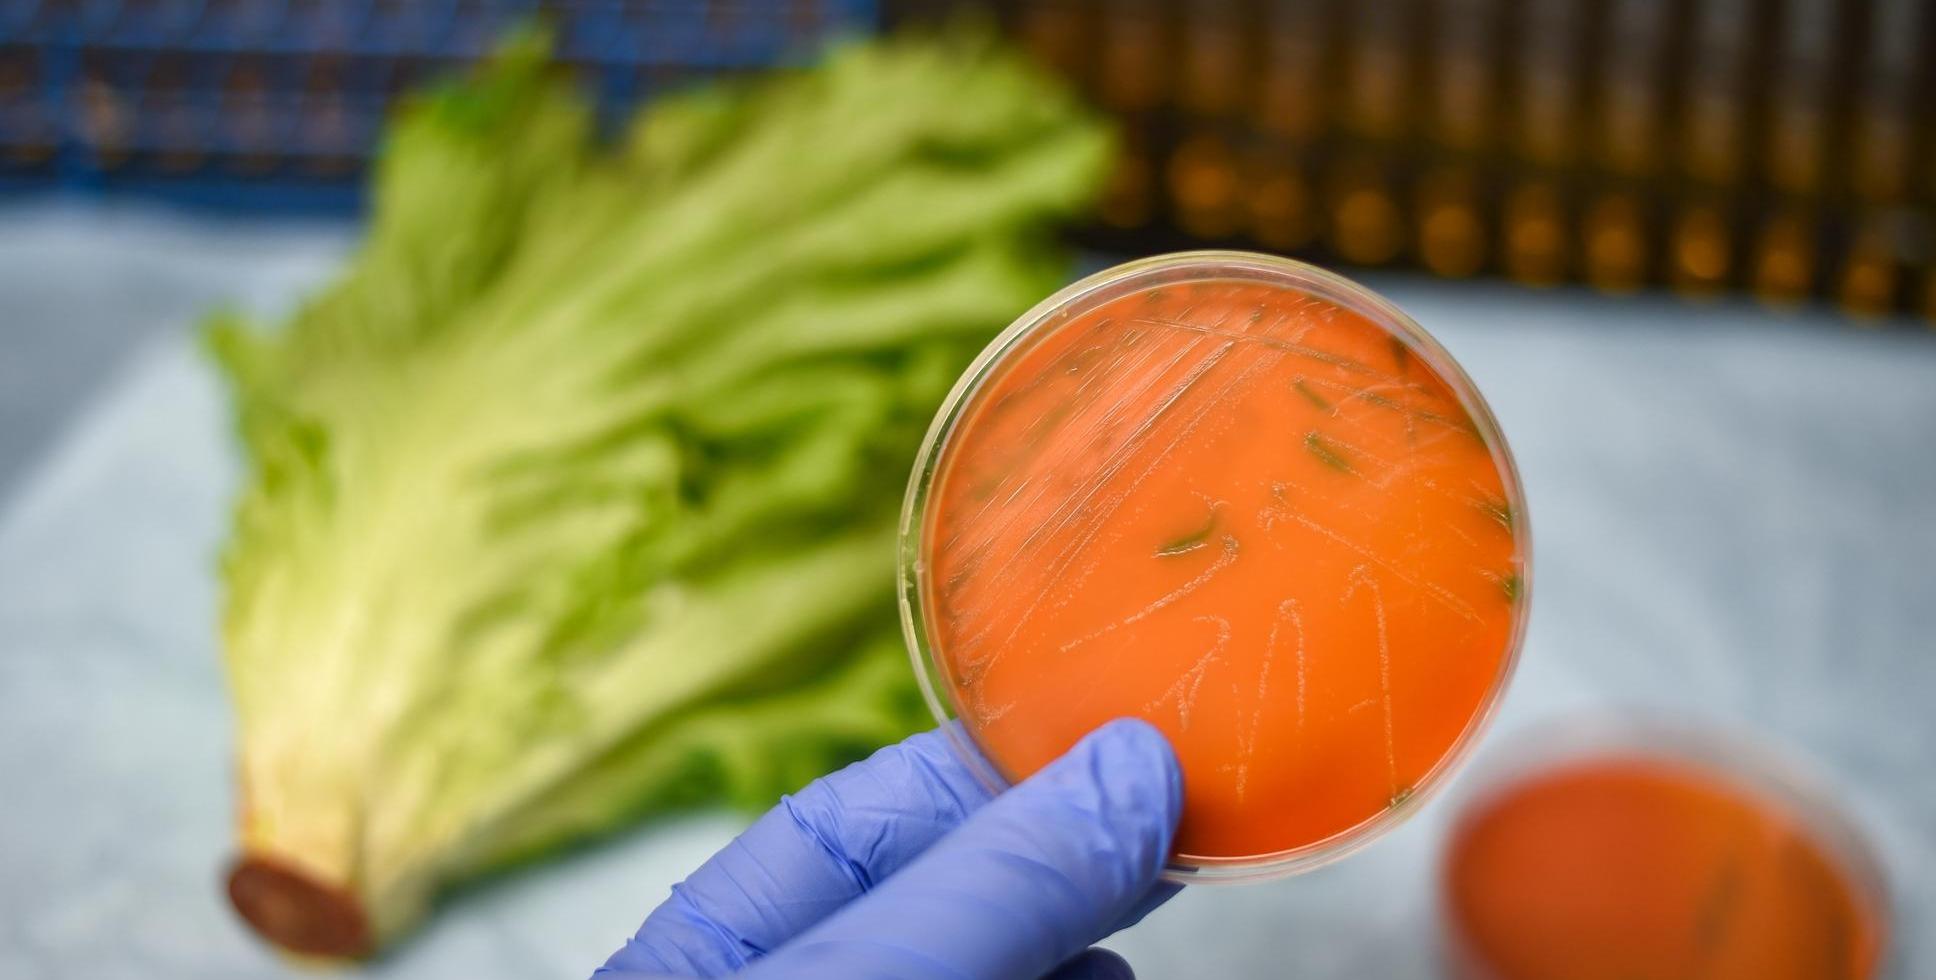

ADITI MALHOTRA MANAGING EDITOR










































































































































































































































































































































































































































































































































































































































































































































































































































ADITI MALHOTRA MANAGING EDITOR
Hello, dear readers!
As we step into this special edition, marking three incredible years of bringing you the best of food, travel, and hospitality, it feels like the perfect time to reflect on what celebration truly means. Beyond the grand feasts and clinking glasses, celebration is a feeling—an experience that lingers long after the lights have dimmed, the music has faded, and the last course has been served. It’s in the anticipation of gathering with loved ones, the excitement of trying something new, and the small moments of indulgence that remind us why life is meant to be savored.
Goa, more than any other place, understands this spirit. Whether it’s an elaborate beachside wedding, a spontaneous sundowner with friends, or a quiet moment of solitude with a well-brewed cup of coffee, celebration here isn’t just about big events—it’s woven into everyday life. There’s a rhythm to the way Goa celebrates, an effortless joy that permeates through its streets, kitchens, and coastal breeze. It’s a place where festivals turn into traditions, where the past meets the present on a plate, and where every season brings its own reason to raise a glass.
This issue is all about that essence of celebration. From indulgent recipes that make every meal feel festive to cocktails that tell a story with every sip, we explore how food and drink remain at the heart of every occasion. We dive into Goa’s reputation as the ultimate celebratory capital of India, a place where people come not just to holiday, but to mark their most cherished milestones. And because we know that celebrations sometimes come with a little overindulgence, we also bring you insights on how to restore balance after a feast, ensuring that you can keep the spirit of revelry alive without the post-party sluggishness.
But beyond the food, the drinks, and the places, what we truly celebrate in this edition is you—our readers, our fellow lovers of good taste, and our partners in this journey. Three years ago, this magazine began as a vision to bring together the best of hospitality, flavors, and experiences. Today, as we turn the pages of this anniversary issue, we look back with gratitude and forward with excitement.
Here’s to many more years of discovering, savoring, and celebrating together. Because life, as we’ve come to realize, is best enjoyed one good meal, one great toast, and one unforgettable memory at a time.
Cheers!
Warmly Yours,
Aditi

Editor in Chief & Publisher
Rajesh Ghadge rajesh@rajeshghadge.com
Managing Editor
Aditi Malhotra aditi@foodandhospitality.org
Contributors
Sunil Malhotra
Armaan Malhotra
Aakash Ghadge
Gauri Ghadge
Niharika Sachdeva
Sneha Deb
Saloni Pai
Design & Layouts
GPDM - A Media Company info@goaprism.com
Photography
Tanmayee Masurkar
Gauri Ghadge
Aakash Ghadge
FOOD & HOSPITALITY MAGAZINE
2nd Floor, Udyog Bhavan, Opp Azad Maidan, Panaji,Goa-403001
+91 8999085172 | info@foodandhospitality.org
SUBSCRIPTIONS & ADVERTISEMENTS
2nd Floor, Udyog Bhavan, Opp Azad Maidan, Panaji,Goa-403001
+91 8999085172 | info@foodandhospitality.org
The Magazine is Published by GOA PRISM DIGITAL MEDIA
Rajesh Ghadge,
2nd Floor, Udyog Bhavan, Opp Azad Maidan, Panaji,Goa-403001
RNI - GOAENG/2020/00441
www.fnhmag.com
Cover Photo Credits
FREEPIK
Stock Images Credits
Image by Freepik












This past February, guests immersed themselves in the vibrant world of Mexican cuisine at Fairfield by Marriott
Goa Benaulim, where the exciting flavors of Mexico came to life in a spectacular celebration. From February 7th to 16th, Kava hosted an Indo-Mexican dinner night brimming with delectable dishes and refreshing drinks, all set against a lively, festive atmosphere that created an unforgettable experience. The Mexican Fiesta at Marriott was the perfect way to spice up the month with a fusion of flavors that guests cherished.
At the heart of this celebration was authentic, rich Mexican cuisine. Diners were transported to Mexico with every bite, as Kava presented a colorful, flavorful buffet featuring traditional Mexican dishes with an exciting twist. This festival brought together the vibrant tastes of Mexico and the bold, aromatic spices of India in a thrilling culinary adventure. Evenings began with an enticing array of handcrafted Enchiladas—delicacies that captured the true essence of Mexican cooking. Each enchilada was paired with a variety of rich sauces and mouthwatering fillings that satisfied every craving. Guests also enjoyed the hearty Chicken and Corn Tortilla Soup, a comforting classic that warmed the soul with every spoonful, offering a taste of Mexico in its purest form. However, the real star of the fiesta was the fusion of flavors
that blended the best of both Mexico and India. Guests experienced the fiery kick of these innovative creations, which combined the boldness of Indian spices with the zest and vibrancy of Mexican flavors, offering an explosion of taste in every bite.
A highlight of the fiesta was the taco haven. The live taco counter allowed guests to build their dream taco, bringing flavors to life as they chose their preferred fillings. Skilled chefs crafted each meal right before their eyes, allowing diners to interact with the process and personalize their dish to perfection. Options like Al P a s t o r a s w e e t a n d s a v o r y sensation—Carnitas, slow-cooked to tender perfection, and Barbacoa, rich with smoky flavors, made each taco a journey of deliciousness. Wrapped in soft tortillas, topped with fresh salsas, and finished off with a squeeze of lime, these tacos ignited the senses with every bite.
No fiesta was complete without a celebration in a glass! Marriott's expertly crafted cocktails delighted guests, each a burst of creativity and flavor. From bold margaritas to inventive blends, every drink was designed to take taste buds on a memorable journey. Whether enjoying a refreshing margarita or trying something new, these cocktails perfectly complemented the rich, vibrant dishes. And when the meal came to an end, guests indulged in Marriott's irresistible churros—a crispy, golden treat on the outside and a soft, warm delight on the inside. Rolled in cinnamon sugar and served with a rich, velvety chocolate dip, these churros provided the perfect sweet finish to the fiesta.
This past February, Fairfield by Marriott Goa Benaulim delivered an unparalleled experience of food, drinks, and festive fun. Whether diners were fans of traditional Mexican fare or looking to explore new flavor combinations, the Mexican Fiesta proved to be an unforgettable culinary adventure. The event celebrated the vibrant culture, spice, and excitement of Mexico right in the heart of Goa.
The special event at Fairfield by Marriott Goa Benaulim was curated by Surender Dobal, the Junior Sous Chef, and supported by a talented culinary team, including Lakhi Routh, Sourabh Patil, Roucell D'Souza, and Vikesh Baghel. This group of chefs delivered an unforgettable dining experience, showcasing their culinary expertise and passion for flavor.
A fiesta of flavors was enjoyed by all—those who visited Kava from February 7th to 16th experienced a taste of Mexico like never before!


Valentine's Day at Kava, nestled within the luxurious
Fairfield by Marriott Benaulim, Goa, unfolded as an evening of unparalleled romance and indulgence.
From 7 PM to 11 PM, guests stepped into a world where love was not only celebrated but beautifully orchestrated in every detail—from the candlelit ambiance to the exquisite culinary artistry.
As couples arrived, the warm glow of candlelight bathed the venue in soft golden hues, setting the stage for an intimate and unforgettable experience. Each flickering flame evoked cherished memories, transforming the night into an immersive journey where romance took centre stage. Kava's thoughtfully curated ambiance ensured that every guest felt the essence of love woven into the very fabric of the evening. Live melodies filled the air, enhancing the atmosphere with a soundtrack of nostalgia and passion. Soothing jazz notes, timeless love ballads, and soul-stirring rhythms created an enchanting backdrop, making each moment more magical. The music wasn't merely entertainment; it became an extension of the emotions shared between couples, elevating the evening into a truly special affair.
Guests indulged in a meticulously crafted gastronomic experience, where every dish bore the hallmark of passion and culinary mastery. The lavish dinner buffet delighted the senses with a symphony of flavors, from exquisitely plated appetizers to decadent main courses, each creation telling a story of refinement and excellence. The curated menu celebrated
love through its thoughtful presentation and rich, nuanced flavors, ensuring that the evening was as much a feast for the heart as it was for the palate.
Raising a toast to love, guests sipped on signature Valentine's cocktails and mocktails, each expertly crafted to mirror the vibrancy and uniqueness of their connections Whether enjoying a delicate fruit-infused mocktail or a sophisticated cocktail with a refined twist, every sip elevated the celebration, adding a touch of elegance to the evening.
A night of romance would not have been complete without a touch of indulgence. The opulent dessert selection provided the perfect finale to an extraordinary evening. Handcrafted chocolates, artisanal pastries, and exquisite confections tempted the taste buds, each as visually stunning as it was delectable. A highlight of the night was the live interactive dessert stations, where couples created their own sweet masterpieces, adding a playful and personal touch to their celebration.
At Kava, Valentine's Day was more than just a dinner—it was an experience of connection, laughter, and shared joy. It was a moment to pause, savor the romance, and celebrate love in its purest form, leaving guests with memories that would linger long after the night had drawn to a close.


In a groundbreaking initiative aimed at addressing the
critical issue of air pollution, Nirvana Being, a leader in clean air solutions, has partnered with Greenr Café, a fastgrowing eatery chain renowned for its plant-forward and health-conscious dining. This collaboration introduces “Pure Air Zones” at Greenr Café locations, ensuring a safe, pollution-free dining experience for patrons.
At each Greenr Café outlet, patrons are greeted by real-time displays of air quality indicators such as AQI (Air Quality Index), PM2.5, and CO2 levels, both indoors and outdoors. These transparent displays reaffirm the brand's commitment to environmental accountability and provide diners with peace of mind, knowing they are breathing clean air while enjoying wholesome food.
The initiative is powered by advanced ventilation, filtration, and automation systems installed by Nirvana Being. These systems work continuously to maintain healthy air quality levels indoors, protecting guests from the harmful effects of outdoor pollution.
Highlighting the importance of clean air in public spaces, Jai Dhar Gupta, Founder of Nirvana Being, said:
“As more people experience health complications due to toxic air, there is a growing demand for safe spaces where they can dine and gather without compromising on health Our collaboration with Greenr Café reflects a shared vision to offer patrons clean air they can trust, setting a new benchmark for health and safety in India's hospitality sector.
Our aim is to inspire other businesses to adopt similar clean air standards, making indoor air quality a priority in all public spaces for the well-being of our communities.”
Greenr Café has long been committed to holistic wellness, focusing on quality food and water as key pillars. Through this partnership, the brand has expanded its mission to include clean, breathable air as a core part of its offering. This step not only enhances the café's health-conscious ethos but also positions it as a pioneer in creating eco-conscious public spaces.
The partnership between Greenr Café and Nirvana Being is not just about improving the café experience—it's a call to action for the broader hospitality and public space sectors.
The collaboration hopes to inspire other businesses to prioritize health-first, pollution-free spaces across India by showcasing how advanced clean air solutions can transform indoor environments.
With “Pure Air Zones” now operational at Greenr Café's Greater Kailash and Vasant Vihar branches, the initiative is setting a new standard for how public spaces can address environmental challenges while enhancing customer experiences.











By Sneha Deb
The sizzle of garlic in hot oil, the vibrant crimson
of a perfectly ripe tomato, the earthy aroma of freshly baked bread- food is a symphony for the senses, a masterpiece painted on the canvas of our palates. More than mere sustenance, food is a language spoken across cultures, a story told in flavors, textures and shared meals. It is this narrative
that the true beauty of food resides. From the intricate artistry of Japanese Kaiseki to the comforting warmth of Italian Lasagna, food embodies the heart and soul of a culture, a legacy passed down through generations.
Focusing on artistry and craftsmanship : A perfectly plated dish is a work of art, a testament

to the chef’s skills and creativity. The beauty of food lies not only in its taste but also in its presentation, a visual feast for the eyes. The delicate swirl of cream in a latte, the twisted pattern on a hand-rolled dumpling, even the simplest dishes can possess a captivating beauty, a testament to the artistry of one’s creation. Food has a way of weaving itself into our memories, evoking feelings of nostalgia, comfort and joy. It is in these emotional connections that we discover the true elegance of food.
Food photography has evolved from a simple record of dishes to a powerful art form, captivating audiences and driving culinary trends. It’s more than just pointing a camera at a plate, it is about telling a story, evoking emotions and making mouths water.
It is crucial for us to understand the core principles of food photography :
Storytelling – Every food picture should tell something. What is the dish? Where has it come from? What emotions does it evoke? Consider the context and narrative you want to convey.
Aesthetics – Food photography is about capturing the beauty of that particular dish. This involves careful attention to composition, lighting, color, texture and styling.
Technical Proficiency – Understanding your camera settings, lenses and lighting equipment is essential for achieving high quality images.
Camera – A DSLR or mirrorless camera offers greater control over settings and image quality.
Lenses – Macro lenses are ideal for capturing close up details, while prime lenses with wide apertures create amazing bokeh and perform well in low light. A zoom lens can offer much flexibility.
Tripod – A tripod is crucial for sharp images especially in low light or when using slow shutter speeds.
Lighting – Natural light is often preferred for its soft, diffused quality. However, artificial lighting, such as strobes or softboxes can be used to create specific effects. Reflectors and diffusers help control and shape light.
The most crucial element in food photography is lighting Natural light, especially soft diffused sunlight is often preferred for its ability to showcase the food’s true colors and textures. Artificial lighting can be used to create dramatic effects but it requires careful manipulation to avoid harsh shadows and unnatural hues.
Vibrant, natural colors are key to making food look appetizing. Understanding color theory and using complementary colors can enhance the visual appeal of the dish.

Different angles can highlight different aspects of a dish. Shooting from above showcases the layout and arrangement, while shooting from the side emphasizes height and unique textures of the item.
Using props like plates, cutleries, fabrics, flowers and backgrounds can help set the scene and tell an exciting story. They can add context and personality to the image.
Food photography has come a long way since it’s early. From simple, straightforward shots to highly stylized and artistic compositions, the genre has constantly evolved. The rise of social media platforms like Instagram, Facebook has further fueled its popularity, with food photography becoming an integral part of our online culture.
Food photography plays a supreme role in various industries.
In advertising – Outstanding food pictures are used to entice consumers and promote products.
For Restaurants – High quality food images on menus and websites can attract customers and increase sales.
Publishers & Publishing – Cookbooks, magazines and blogs rely on stunning food photography to showcase recipes and inspire readers.
Food photography is a rewarding field that allows you to express your creativity and passion for food.
By mastering the techniques of lighting, composition, styling and editing, you can create mouthwatering images that capture the essence of every dish.
Art of Food Styling – Making culinary creations camera ready.
Food styling is the art of presenting food in a visually appealing way for photography or videography. A skilled food stylist can make a simple plate of pasta look like a culinary masterpiece, enticing viewers to crave a taste.
Food stylists are the unsung heroes behind those dazzling images of dishes you see on magazines, advertisements and cookbooks. They are culinary artists who understand the science and art of food presentation. Their job goes beyond simply arranging items on plates. It involves meticulous planning, preparation and execution to create visually stunning and believable pictures.
Food stylists have a variety of tools at their disposal to help them create wonderful images. These tools can indulge –
Tweezers & Brushes: for precise placement of small items and delicate adjustments.
Spray Bottles: for adding moisture or creating a dewy look on food.
Heat Guns: for melting cheese or browning the surfaces of food items.










By Sneha Deb
Food is more than just sustenance, it is a cultural expression, a reflection of history, geography and traditions. From the bustling street food stalls of Southeast Asia to the refined elegance of French gastronomy, the world is a veritable feast of flavors waiting to be explored. The world is a culinary playground, offering a kaleidoscope of flavors, aromas, texture and taste. By exploring the diverse cuisines of different cultures, we can not only satisfy our taste buds but also gain a deeper understanding of the world around us. One should
continue to savor the world’s culinary treasures. A country’s cuisine depends on several different factors. Let us go through few of them to understand better :
Climate & Terrain – The availability of ingredients plays a crucial role. Coastal region boasts fresh seafood, while fertile plains abound with grains and vegetables. And climates often feature droughtresistant crops and flavorful spices.
Trade Routes – Historical trade routes have been instrumental in spreading culinary traditions. Spices
from India reached Europe via the Silk route, while the Columbian exchange introduced ingredients like potatoes and tomatoes to the old world. Religion & Traditions – Religious beliefs often dictate dietary restrictions, as seen in vegetarianism in Hinduism and the Kosher laws of Judaism. Cultural traditions such as celebrations & festivals have their own associated dishes. The world of cuisine is a vast and ever evolving tapestry. There are many different cuisines, with estimates ranging from 20-30 major culinary traditions. Each of them has a unique cooking method, a blend of several ingredients and flavors. Still there are countless hidden gems waiting to be discovered. While some cuisines enjoy global acclaim, others remain relatively unknown. We have brought you five cuisines that are seemingly underrated in today’s world and deserve every bit of your attention.
1. Peruvian Cuisine: While Peruvian food has gained some popularity with dishes like Ceviche, it is still relatively unknown compared to other Latin
American cuisines. Aji Amarillo, a bright yellow chili pepper, is a key ingredient which adds a unique flavor to dishes like Aji de Galina (creamy chicken stew) and Causa Rellena (layered potato dish).
2. Ethiopian Cuisine: The cuisine is often overshadowed by North African and Mediterranean flavors but it offers a unique and flavorful experience. Injera, a spongy flatbread is used as a utensil to scoop up stews and curries like Doro Wat and Tibs (stir fried meat). The spice blend Berbere adds a warm kick to many dishes.
3. Ukrainian Cuisine: Often overlooked in favor of neighboring cuisines, Ukrainian food offers hearty and comforting dishes perfect for colder climates. Borscht, a beet soup, is a staple, as are Pierogi (dumplings) filled with various savory or sweet fillings. Salo, cured pork fatback is a beloved ingredient.
4. Kashmiri Cuisine: The rich culinary tradition of the Kashmiri pandits comprises vegetarian


delicacies like Godje Rajma. The food is a treasure trove of flavors and textures, reflecting the region’s unique blend of Central Asian and Indian influences. Some iconic Kashmiri dishes include Rogan Josh, Yakhni, Kahwa and much more.
5. Maldivian Cuisine: The island nation’s cuisine is heavily influenced by Sri Lankan and Indian flavors. Coconut milk is a key ingredient, used in curries and Rihaakuru (fish paste). Garudhiya, a fish soup, is the national dish. The Maldivian diet also features a lot of seafood, fresh fruits and vegetables.
These are just a few of the many underrated cuisines around the world. Each one of them offers a unique, special and flavorful experience, waiting to be discovered. The world of cuisines is vast and varied with countless hidden gems. Exploring these lesser-known culinary landscapes offers a unique opportunity to expand our palates, challenge our preconceptions about food and connect with cultures on a deeper level.




















































































































































































































































































































































































Goa has long been a beacon of hospitality, drawing travelers from around the world to its sun-kissed beaches, vibrant nightlife, and culinary delights. Recognizing the sheer scale and impact of the food and hospitality industry in Goa, Goa Prism Digital Media embarked on a journey to create the state's first dedicated Food & Hospitality Magazine. It was during the waning days of the pandemic, a time when the industry was finding its feet again, that we launched our website, providing a platform for the revival stories of Goa's biggest industry. In February 2022, we launched the first edition of the magazine. Today, we celebrate three years of unwavering dedication, storytelling, and excellence in capturing Goa’s culinary and hospitality evolution.
From its inception, the magazine set out to do more than just report on the industry—it aimed to shape the narrative, highlight emerging trends, and give voice to the chefs, hoteliers, and entrepreneurs who



define Goa’s hospitality landscape. Over the last three years, we have chronicled the resurgence of legendary establishments, the rise of boutique experiences, and the innovative efforts of industry pioneers in redefining Goa’s hospitality sector. This journey has also paralleled a significant transformation within Goa itself. The state has witnessed an evolution in its culinary scene, embracing not just traditional Goan flavors but also global influences. The past three years have seen the emergence of sustainable dining, farm-totable concepts, artisanal cuisine, and fusion gastronomy, making Goa a melting pot of flavors. Goa’s Culinary Evolution: The New Wave of Dining
Sustainability has become a cornerstone of Goa’s dining culture, with farm-to-table restaurants and eco-conscious eateries leading the way. The demand for organic, locally sourced ingredients has pushed chefs to innovate, creating menus that celebrate seasonal produce and authentic flavors.


Additionally, global influences have played a crucial role in reshaping Goa’s culinary landscape. Traditional Goan fare now sits alongside avantg a r d e c r e a t i o n s i n s p i r e d b y Mediterranean, Pan-Asian, and European cuisines. The blending of flavors has not only attracted discerning travelers but has also allowed local chefs to make a mark on the international stage.
Hospitality Reinvented: Luxury, Wellness, and Technology
Parallel to the food revolution, Goa’s hospitality industry has undergone a radical transformation. Travelers today seek experiential stays, boutique luxury, and wellness retreats, shifting away from traditional hotel accommodations As a response, resorts and boutique hotels have reimagined their offerings to focus on personalized experiences, immersive wellness programs, and a strong c o m m i t m e n t t o e c o - f r i e n d l y practices.
Technology has also played a pivotal role in redefining hospitality. From AIpowered concierge services to smart room automation, the integration of tech has enhanced guest experiences while maintaining a seamless blend of convenience and luxury The postpandemic era has also underscored the importance of contactless checkins, virtual concierge services, and curated digital experiences to cater to the evolving needs of travelers.
The Future of Food & Hospitality in Goa
Looking ahead, the next three years promise to be an exciting phase for Goa’s food and hospitality industry. Experts predict a further rise in: AI-driven hospitality – Smart technology enhancing guest services


and operational efficiency.
Sustainable tourism – A deeper commitment to green practices, reducing carbon footprints, and ecoconscious business models.
Culinary tourism – Goa cementing itself as a global food destination through immersive dining experiences, food festivals, and gastronomic tourism.
Experiential dining – Multi-sensory dining experiences, chef’s table exclusives, and themed culinary adventures that go beyond traditional restaurant formats.
This magazine’s journey has been nothing short of extraordinary, and as we step into our fourth year, we extend our heartfelt gratitude to our readers, industry partners, and contributors who have been part of this adventure. Your unwavering support and engagement have fueled our passion for telling the stories that matter.
Looking ahead, we have exciting plans for new collaborations, feature expansions, and interactive digital content that will continue to spotlight the very best of Goa’s food and hospitality industry.
As we celebrate this milestone, we also invite our readers to be a part of this journey. Share with us your favorite Goa food and hospitality experiences, and let’s continue to build a community that appreciates and nurtures the essence of Goan hospitality. Here’s to the future—one that is delicious, luxurious, and always inspiring!







By Aditi Malhotra
A celebration is never complete without a grand dessert, and this dark chocolate torte is as decadent as it gets. Infused with roasted hazelnuts and finished with delicate gold leaf, this rich, slightly bittersweet, nutty delight is the perfect way to end a meal on a luxurious note.
200g dark chocolate (70% or higher), chopped
3/4� cup unsalted butter
3/4 cup sugar
4 large eggs
1/2 cup ground roasted hazelnuts
1/2 cup almond flour
1 tbsp espresso powder
1 tsp vanilla extract
A pinch of sea salt
F Melt the dark chocolate and butter together in a heatproof bowl over simmering water (double boiler method) until smooth. Remove from heat and stir in sugar, vanilla, and espresso powder.
F Whisk the eggs separately until light and fluffy, then gradually fold them into the chocolate mixture.
F Add the ground hazelnuts, almond flour, and a pinch of sea salt, mixing until well incorporated.
F Pour the batter into the prepared pan and bake for 20-25 minutes until just set but still slightly gooey in the center.
F Once cooled, gently place edible gold leaf on top for a show-stopping finish. Serve with a dollop of whipped cream or crème fraîche.
Pro Tip: For an extra celebratory twist, serve this torte with a drizzle of warm dark chocolate ganache or a side of raspberry coulis.

By Aditi Malhotra
Some celebrations deserve an extra touch of luxury, and what better way to do that than by combining the richness of saffron with the elegance of Champagne? This risotto is creamy, indulgent, and infused with subtle floral notes that make it stand out from traditional versions. Perfect for an intimate anniversary dinner or a sophisticated gathering, this dish embodies the art of slow cooking and refined flavors.
1 1/2 cups Arborio rice
4 cups vegetable or chicken broth, warmed
1 cup dry Champagne or sparkling wine
1 small onion, finely chopped
3 tbsp butter
2 tbsp olive oil
1/2 tsp saffron threads soaked in 2 tbsp warm water
1/2 cup grated Parmesan cheese
1/2cup heavy cream (optional, for extra richness)
Salt & white pepper to taste
Microgreens or edible flowers for garnish
F Heat olive oil and 1 tbsp butter in a deep pan over medium heat. Sauté the onions until translucent but not browned.
F Stir in Arborio rice and toast lightly for about 2 minutes until the grains are coated and slightly glossy.
F Pour in the Champagne, stirring constantly, and let it simmer until almost fully absorbed.
F Gradually add the warm broth, one ladle at a time, stirring continuously until the liquid is absorbed before adding more. This process creates the creamy consistency risotto is known for.
F Halfway through, add the saffron-infused water for a rich golden hue and delicate aroma. Continue stirring and adding broth until the rice is cooked but still slightly al dente.
F Reduce heat and stir in Parmesan, heavy cream (if using), and the remaining butter. Adjust seasoning with salt and white pepper.
F Serve immediately, garnished with microgreens or edible flowers, and raise a glass to pure indulgence!

By Sneha Deb
Food wastage is a significant global issue with farreaching consequences for the environment, economy and society. It occurs at every stage of the food supply chain, from production and processing to retail and consumption.
One of the main causes of food waste is overproduction, where farmers produce more food than can be sold or consumed. This can be due to unpredictable weather patterns, fluctuating market prices, and a lack of efficient storage and transportation facilities. Additionally, strict cosmetic standards imposed by retailers often lead to perfectly edible fruits and vegetables being
discarded simply because they do not meet aesthetic criteria.
In households, food waste is often caused by poor meal planning, improper storage and confusion over expiration dates. Many people buy more food than they need, leading to spoilage and unnecessary waste. Large portions served in restaurants and at home often result in leftovers not properly stored or reused.
The environmental effect of food waste is substantial. When food is thrown away, it ends up in landfills, where it decomposes and releases methane, a potent greenhouse gas that contributes
to climate change. Moreover, the resources used to produce the wasted food, such as water, land and energy are also squandered.
The economic costs of food waste are also significant. It represents a loss of valuable resources and revenue for farmers, businesses and consumers. Also, the cost of disposing of food waste in landfills adds to the financial burden.
Addressing food waste is a multi-faceted approach involving all stakeholders. Farmers can adopt better harvesting and storage techniques to reduce losses during production. Retailers can relax cosmetic standards and offer discounts on slightly imperfect products Consumers can plan meals carefully, store food properly and compost food scraps. Governments can implement policies to promote food waste reduction and support initiatives that recover and redistribute surplus food. Food waste reduction can happen at every stage of the food supply chain, from farm to table.
Here are some key methods to reduce food waste-At the farm level
Improved harvesting techniques- Farmers can use more precise harvesting methods to minimize damage to crops and reduce the amount of food left in the fields.
Diversification of crops- Planting a variety of crops can help farmers mitigate losses due to weather or pest issues.
Better storage and transportation- Investing in proper storage facilities and transportation can prevent spoilage and extend the shelf life of produce.
Utilizing by-products- finding creative ways to use by-products from food processing, such as turning fruit peels into compost or using vegetable scraps for animal feed.
Reducing packaging waste- using minimal and recyclable packaging can help reduce overall waste.
Improving inventory management- retailers can use

data to predict demand and avoid overstocking, which further leads to spoilage.
Educating consumers- providing information on proper food storage and meal planning can help reduce waste at the consumer level. Donating unsold food- Partner with food banks or charities to donate the unsold but still edible food.
Meal planning- planning meals ahead of time can help avoid buying more food than needed. Proper food storage- understanding how to store different types of food can extend their shelf life and prevent wastage.
Composting- Composting food scraps and yard waste can reduce the amount of waste going to landfills.
Reducing portion sizes- offering smaller portion sizes in restaurants and cafeterias can help stop excessive food waste.
Educating staff & patrons- raising awareness about food wastage and providing tips on reducing it can make a big difference.
By implementing these methods at each stage of the food supply chain, we can primarily lessen the high waste rate of food items and its negative impacts on the environment, economy and society. Reducing food waste has a wide range of benefits that positively impacts the world. By doing so, we can create a more sustainable food system that would also improve air and water quality in urban areas and fix soil health, decreasing the need for chemical fertilizers and pesticides.









By Niharika Sachdeva
A shack, a haven by the sea. A symbol of Goa's harmony. It whispers tales of days once new. Where laughter echoed, waves would roar. Now, they stand in silence, worn and grey, as tourists drift far away. Once a haven, now a dream. Lost to the changing, fickle stream. A place of memories, now at rest. The shack, once thriving, is now a guest. Yet in its heart, the stories stay of golden nights and brighter days, but even shacks must face the tide. As fortunes shift and dreams subside. Still, in the wind, its spirit calls. A reminder of its once proud
walls.
Once a bustling paradise for tourists, Goa is now facing an unsettling decline in its tourism industry, with its beloved beach shacks bearing the brunt of the downturn Once vibrant hubs of activity, offering everything from fresh seafood to chilled cocktails, these shacks are now closing their doors as fewer visitors flock to the coastal state. Prior to the onset of the COVID-19 pandemic, we were already witnessing a noticeable decline in both domestic and international tourists, raising
concerns among shack owners and local businessmen. A significant number of beach shacks, particularly in popular areas like Calangute, had to close their doors due to a drop in visitors. International tourist numbers also declined, further affecting the local economy. Known for its laid-back, Western-inspired culture, Goa had long been a favorite destination for travelers seeking a unique blend of sun, sea, and vibrant lifestyle. However, in recent years, the state's appeal has been dimmed by growing concerns about safety and security as crime rates have steadily risen. Additionally, the state has been increasingly impacted by erratic weather patterns, leading to widespread disruptions and damage. Together, these factors have posed significant challenges to Goa’s tourism industry, raising questions about its future as a top tourist destination. As the number of tourists dwindled, shack owners found it increasingly tough to stay afloat. With a decline in visitors, they struggled to manage daily expenses, including purchasing supplies,


paying rent for their land, and compensating their staff. The seasonal aspect of tourism in Goa meant that these owners relied heavily on busy periods, such as the winter months and holiday seasons, to compensate for leaner times throughout the year. When these peak seasons began to attract fewer guests, their challenges intensified.
The shutdown of beach shacks has affected not just the owners but also the surrounding communities that depend on these establishments for their income Numerous shack owners hire seasonal staff, including cooks, servers, and cleaning personnel, who rely on the earnings made during the busy tourist season. The drop in business has resulted in job losses, putting extra pressure on the local job market. Additionally, shack owners typically source their supplies from nearby vendors, meaning the impact of their closure spreads to
other areas of the economy, including agriculture, fishing, and transportation.
To tackle these challenges, initiatives have been launched to rejuvenate Goa's tourism and, consequently, its beach shack economy. These efforts focus on encouraging sustainable and ecofriendly tourism, providing incentives for local t
infrastructure.
The decline of shack owners in Goa presents a multifaceted challenge that mirrors significant changes in tourism trends, safety issues, and environmental obstacles. For numerous small, family-operated enterprises, the outlook remains precarious as they contend with a situation where the elements that once established Goa as a favored tourist hotspot are now facing growing threats.



By Aditi Malhotra
Celebrations are more than just events; they are moments that leave lasting memories. And at the heart of every great celebration is a combination of flavors, aromas, and the perfect toast. Whether it’s the pop of a Champagne bottle, the smoky intensity of an Old Fashioned, or the vibrant tropical notes of a Goan feni cocktail, the drinks we raise play an
essential role in how we commemorate special occasions. But a drink is never just a drink—it’s an experience, and today’s cocktail culture is elevating celebrations in ways we never imagined. Gone are the days when celebratory drinks meant simply pouring a glass of bubbly or serving up a round of classic cocktails. Modern mixology has

transformed the way we drink, making cocktails part of the celebration itself. From theatrical smoke-infused drinks to glow-in-the-dark elixirs, the art of crafting cocktails has become an immersive, multi-sensory experience. Whether it’s a high-energy wedding party, an intimate anniversary dinner, or a New Year’s Eve bash, the drinks we sip have evolved into something far beyond mere beverages—they are centerpieces of the occasion.
Historically, celebratory drinks were tied to luxury. Champagne, for example, was once reserved for royalty and aristocrats, a drink symbolic of grandeur and excess. Over time, the association between Champagne and celebration became so ingrained in culture that even today, a simple toast feels incomplete without its effervescence. Whiskey, too, has long been associated with milestone moments, its deep, warming notes making it the perfect drink for reflective celebrations.
But today’s cocktail scene is rewriting the rules.

Celebratory drinks are no longer just about tradition; they are about experience, innovation, and creativity. Take, for instance, the "Glitter Fizz", a sparkling wine cocktail infused with edible gold dust, making it shimmer under party lights. Or the "Smoking Negroni", where the infusion of cherrywood smoke adds depth and drama to every sip. Drinks today don’t just complement a celebration; they become part of it.
The Role of Food in a Celebration-Ready Cocktail Experience
Of course, no cocktail experience is complete without food. A truly festive dining experience isn’t just about what’s served on the plate—it’s about how flavors interact, contrast, and elevate the drinks they are paired with.
Take Goan chorizo-stuffed mushrooms with a tropical rum punch—the smoky heat of the chorizo balances beautifully against the refreshing sweetness of the drink. Or a spiced chocolate
dessert paired with a robust espresso martini, where the bitterness and warmth play off each other in perfect harmony. The synergy between cocktails and cuisine is what transforms a gathering into a true culinary celebration.
From experiential cocktail menus featuring personalized drinks tailored to guests’ personalities, to tableside mixology where bartenders craft drinks right before your eyes, the landscape of celebration is constantly evolving. Multi-sensory dining, infused spirits, and playful garnishes are making modern celebrations unforgettable, proving that today’s cocktails aren’t just meant to be drunk—they’re meant to be experienced.
As we toast to another year of memories, flavors, and milestones, one thing is clear: celebrations are no longer just about drinking they’re about indulging in an experience that lingers long after the last sip.



By Sneha Deb
A wise saying reminds us, “When the diet is wrong, medicine is of no use; when the diet is right, medicine is not needed.” In today's fast-paced world, prioritizing healthy eating isn't a mere choice—it's a necessity.
Nestled along the LKRB Path in Guwahati, Assam, Clean & Green Café has become a sanctuary for
those who crave wholesome yet flavorful cuisine. With a thoughtfully curated menu featuring avocado and egg toast, nutrient-rich salad bowls, hearty oat dishes, and vibrant smoothie bowls, this café offers a refreshing take on mindful eating.
Guwahati: A Cultural & Culinary Crossroad Recognized as the Gateway to Northeast India,
Guwahati is a bustling commercial hub set along the Brahmaputra River. The city's rich cultural heritage, ancient temples, lush tea gardens, and thriving wildlife reserves make it a fascinating destination. Amidst this vibrant backdrop, Clean & Green Café has established itself as a pioneer in the city's evolving food scene, catering to those seeking nutrition without compromising on taste.
Freshness & Purity: The Core Philosophy
At Clean & Green, quality is paramount. Every dish is crafted using organic, unprocessed, and natural ingredients, ensuring that customers receive food in its purest form. The café's culinary approach involves preparing elements from scratch, preserving their nutritional integrity. Even the salad dressings are handmade, maintaining the original flavors without artificial additives.
To promote a healthier lifestyle, refined sugar is replaced with natural alternatives like jaggery powder and low-calorie honey, while preservatives and artificial enhancers are strictly avoided. This commitment to clean eating makes Clean & Green a haven for those who prioritize gut-friendly,
nutrient-dense meals.
The Visionary Behind Clean & Green: Surya Baruah Entrepreneur Surya Baruah, the driving force behind Clean & Green, has always been passionate about hospitality. After a five-year tenure in the airline industry, she pursued her dream of creating a space that blends warmth, wellness, and exquisite cuisine. Surya's journey began in her own kitchen, where she experimented with nutritious recipes. Encouraged by growing demand and positive feedback, she transitioned into a full-scale business. With a strong foundation in marketing, she strategically built Clean & Green Café, bringing her vision to life in her hometown.
As someone managing Polycystic Ovary Syndrome (PCOS) herself, Surya understands the profound impact of diet on overall well-being, particularly for women. This personal experience has shaped Clean & Green's menu, ensuring it caters to those seeking hormone-balancing, high-protein, and plant-based food options.
Understanding PCOS & The Role of Nutrition Polycystic Ovary Syndrome (PCOS) is a common

hormonal disorder affecting women worldwide, with symptoms ranging from menstrual irregularities and weight gain to acne and hair loss. Global prevalence estimates range from 4% to 12%, while in India, cases vary between 2% to 35%.
Studies highlight that diet plays a crucial role in managing PCOS. Reducing processed foods and incorporating whole grains, leafy greens, and protein-rich meals can significantly alleviate symptoms. At Clean & Green, every dish is thoughtfully designed to support a balanced and nutritious lifestyle, making healthy eating an effortless choice.
Commitment to Quality & Affordability
With an unwavering focus on quality, Clean & Green ensures that every ingredient meets the highest standards. From freshly sourced produce to handcrafted dressings and sugar-free recipes, the café caters to health-conscious diners without sacrificing flavor.
Despite using premium ingredients, pricing remains accessible, ensuring a broad audience can enjoy its offerings. This approach has positioned Clean & Green as a go-to destination for both wellness enthusiasts and casual diners seeking nutritious alternatives.
Expanding Horizons: From Guwahati to Bangalore
Surya Baruah's journey has been one of perseverance and resilience. She believes that every challenge brings a lesson, and her approach to obstacles is calm and methodical. Having established a loyal customer base in Guwahati, she now envisions expanding Clean & Green to Bangalore, a city known for its thriving café culture and health-conscious community.
Her mission remains steadfast: to transform people's perception of healthy eating by demonstrating that organic, protein-rich, and lowcalorie food can be equally indulgent and satisfying.
Redefining Healthy Dining with Clean & Green
In a world dominated by ultra-processed, convenience-driven meals, Clean & Green Café stands as a beacon of change. With a commitment to fresh, natural, and handcrafted cuisine, it's not just a café it's a movement towards mindful, wholesome living.
As more people embrace the philosophy of clean eating, Clean & Green continues to inspire, proving that wellness and gastronomy can go hand in hand.






















By Sunil Malhotra
Celebrations come with abundance, and sometimes, that abundance comes at a cost—an overindulgent meal, one too many cocktails, or an unplanned late-night binge. As enjoyable as these moments are, they often leave us feeling bloated, sluggish, or uncomfortable. But fear not—Goan wisdom has long had remedies for post-celebration woes, and it turns out, they work like magic.
Heavy, rich meals—especially those with fried foods, sugar, and alcohol—can put immense stress on the digestive system. The body struggles to break down excess fats, sugar spikes lead to crashes, and alcohol dehydrates the body, making digestion even slower. The key to recovering from a celebratory feast isn’t deprivation—it’s balance.


Post-Feast Remedies That Actually Work
Kokum Water: A staple in Goan households, kokum is a natural digestive aid that cools the stomach and eases bloating. A glass of kokum-infused water after a meal helps detoxify the body while preventing acidity.
Cumin & Ajwain Tea: This simple combination of cumin and carom seeds, boiled in water, aids digestion and reduces bloating.
Ginger & Lemon Detox Shot: A small shot of fresh ginger juice with lemon and honey can soothe the stomach and reset digestion.
Fermented Foods: Probiotic-rich foods like yogurt, kanji (fermented carrot water), and pickled vegetableshelp restore gut health after excessive eating.
The Art of Enjoying Without Overdoing It
True celebration is about pleasure without discomfort. The trick to avoiding the dreaded food hangover isn’t eating less—it’s eating mindfully, listening to your body, and embracing balance. So, the next time you find yourself indulging in a grand meal, don’t stress about the aftermath—just follow these natural remedies and keep the celebration going.



By Sunil Malhotra
Over the last few decades, ultra-processed foods have taken over supermarket shelves, fast-food chains, and even household kitchens. From instant noodles to packaged snacks and sugary breakfast cereals, these foods are often marketed as convenient, tasty, and affordable. However, growing research suggests that ultra-processed foods could be linked to several health risks, including obesity, diabetes, and even mental health disorders. But does this mean they should be entirely avoided, or is the fear surrounding them exaggerated?
Not all processed foods are unhealthy. The level of processing varies, and many foods undergo some degree of processing before reaching our plates. Milk is pasteurized, whole grains are milled, and vegetables are frozen to retain nutrients—these are all forms of processing. However, ultra-processed foods go a step further They are made with industrially derived ingredients, often contain
artificial additives, and bear little resemblance to their original food sources.
Examples of ultra-processed foods include:
Sugary cereals
Instant noodles
Packaged snacks (chips, cookies, candy)
Soft drinks and energy drinks
Processed meats (sausages, nuggets, salami)
These products often contain preservatives, flavor enhancers, artificial colors, and high amounts of sugar, salt, and unhealthy fats.
One of the biggest concerns surrounding ultraprocessed foods is their link to obesity and metabolic disorders. These foods are often high in refined sugars and unhealthy fats, leading to rapid blood sugar spikes followed by crashes that increase cravings and overall calorie consumption. Additionally, studies have shown that a diet high in ultra-processed foods can increase inflammation in

the body. Chronic inflammation is a risk factor for conditions like heart disease, diabetes, and even certain cancers The presence of artificial additives, preservatives, and emulsifiers may also negatively impact gut health by altering the balance of gut bacteria.
Mental health is another area of concern. Diets high in ultra-processed foods have been linked to a greater risk of anxiety and depression. The high sugar content in these foods can cause fluctuations in mood and energy levels, while the lack of essential nutrients affects brain function.
While many ultra-processed foods should be consumed in moderation, not all of them are inherently bad. Some fortified cereals, protein bars, and plant-based alternatives are processed but still provide essential nutrients. The key is to read ingredient labels and avoid products with excessive additives, artificial sweeteners, and high sodium levels.
Instead of eliminating all processed foods, the goal should be to focus on whole, minimally processed foods whenever possible Cooking meals from scratch using fresh ingredients, choosing whole grains over refined ones, and opting for natural snacks like nuts and fruits can help minimize dependency on ultra-processed options.
Drinking water instead of sugary beverages, replacing store-bought sauces with homemade versions, and being mindful of portion sizes can also make a difference.
Ultra-processed foods have undoubtedly changed the way we eat, making food more accessible and convenient. However, their long-term health effects cannot be ignored. While occasional consumption may not be harmful, reliance on these foods as dietary staples could contribute to several health concerns. The key is balance—understanding what you ’ re eating, making informed choices, and prioritizing whole, nutrient-dense foods whenever possible. Your body thrives on real food, and the closer you stay to nature’s offerings, the healthier you’ll feel in the long run.






















By Sneha Deb
The food industry, while essential for human survival, significantly contributes to various forms of pollution. This pollution occurs at every stage of the food supply chain, from production and processing to transportation and consumption. The consequences are far reaching, impacting the environment, human health and the economy Pollution in the industry is a complex issue with no easy solution. However, by adopting sustainable practices, reducing waste and raising awareness,
we can work towards a food system that is both healthy and environmentally responsible. Food pollution refers to the contamination of food with harmful substances that can pose health risks to consumers. Here are the main types of food pollution:
1. Biological contamination: this occurs when food is contaminated with harmful microorganisms like bacteria, viruses, parasites or fungi. These
microorganisms can cause food borne diseases ranging from mild stomach upset to severe infections. Examples include Salmonella, Listeria etc.
2. Chemical contamination
this happens when food comes into contact with harmful chemicals such as pesticides, heavy metals or toxins. These chemicals can cause poisoning or long-term health issues.
3. Physical contamination
this involves the presence of foreign objects in food such as glass, metal shavings, plastic or dirt. These objects can cause choking, injury or discomfort if ingested.
4. Allergen contamination
this occurs when food allergen like peanuts or gluten unintentionally come in contact with foods that are supposed to contain them. This can trigger allergic reactions in sensitive individuals. It is important to note that cross-contamination, which involves the transfer of contaminants from one food to another, can also occur. This is often
considered a separate category of contamination by some sources.
Food pollution has a significant impact on the environment, the way we produce, process and dispose of food can lead to various forms of pollution, contributing to environmental degradation and climate change.
Pesticide and fertilizer runoff- the excessive use of pesticide and fertilizer in agriculture can lead to runoff into waterways, causing water pollution and harming aquatic ecosystems.
Greenhouse gas emission- livestock farming contributes primarily to greenhouse gas emission, particularly methane which is a potent greenhouse gas.
Deforestation- the expansion of agricultural land, often for livestock or monoculture crops, can lead to deforestation, resulting in habitat loss and reduced biodiversity.
Soil degradation- intensive farming practices can deplete soil nutrients and lead to soil erosion, reducing the long-term productivity of agricultural land.
Landfill methane emission- food waste in landfills decomposes and produces methane, a potent greenhouse gas that contributes to climate change.
Resource waste- food waste represents a waste of the resources used to produce it, including water, land, energy and labor.
Mitigating the environmental impacts of food pollution:
Sustainable agriculture- promoting sustainable agricultural practices such as integrated pest management and crop rotation can reduce pollution and improve soil health.
Reducing food waste- implementing strategies to reduce food waste at consumer, retail and production levels can significantly decrease
environmental impacts.
Sustainable packaging- encouraging the use of sustainable packaging materials and reducing package waste can minimize pollution.
Renewable energy- transitioning to renewable sources in food production and processing can decrease greenhouse gas emission.
The challenge of food pollution demands immediate and concerted action. From farm to fork, we must embrace sustainable practices to safeguard both our health and our planet’s. While the issue of food pollution is complex, solutions exist. By embracing innovation, promoting sustainable agriculture and reducing waste, we can pave the way for a future where food nourishes without harming. Food pollution is a threat we can no longer ignore, the time for action is now.



By Aditi Malhotra
One of the most scenic spots in Kalimpong, Durpin Dara Hill offers a breathtaking panoramic view of the Kanchenjunga range and the Teesta River meandering through the valleys. Perched on this hill is Zang Dhok Palri Monastery, commonly known as Durpin Monastery. This monastery, blessed by the Dalai Lama in the 1970s, houses rare Buddhist scriptures brought from Tibet after the Chinese invasion. The peaceful aura, fluttering prayer flags, and the stunning landscape make it a must-visit spot.
For those fascinated by colonial history and eerie folklore, Morgan House is a perfect place to visit. This 1930s British-era bungalow, now converted into
a heritage stay under the West Bengal Tourism Department, is rumored to be haunted. Overlooking rolling tea gardens, this mansion still carries remnants of the British aristocracy’s extravagant past. Whether you believe in ghosts or not, the charm of this place, with its antique furniture, creaking wooden floors, and mist-laden surroundings, is undeniable.
Standing as one of the highest points in Kalimpong, Deolo Hill offers spellbinding views of the snowcapped Himalayas, lush valleys, and Kalimpong town itself. The best part? It’s far less crowded than other popular hill viewpoints A beautifully maintained park on the hill makes it ideal for picnics, and the crisp mountain air makes it a perfect place to just sit and soak in the scenery. Adventure seekers can also indulge in paragliding from Deolo Hill,

offering a thrilling way to experience the landscape from the skies.
Kalimpong is famous for its flower nurseries, and among them, the Pine View Cactus Nursery is a hidden gem. Home to one of the largest collections of cacti and succulents in Asia, this nursery showcases rare and exotic plants from all over the world. It’s an unexpected delight in a Himalayan hill town and reflects Kalimpong’s longstanding floriculture industry, which exports flowers across India and abroad.
Beyond cacti, Kalimpong’s other nurseries grow orchids, gladioli, and lilies, making it a paradise for plant lovers.
Dr Graham’s Homes isn’t just an educational institution; it’s a historical landmark that has shaped Kalimpong’s identity. Established in 1900 by Scottish missionary Dr. John Anderson Graham, the school was built to provide shelter and education to AngloIndian children. The sprawling 500-acre campus, with its old-school charm, colonial architecture, and a chapel that echoes the past, is worth a visit. It stands as a testament to Kalimpong’s deep-rooted connection with European missionaries and their influence on the region.
The Lepchas are one of the oldest indigenous communities of the Eastern Himalayas, and their culture and traditions are beautifully preserved at the Lepcha Museum in Kalimpong. Unlike most tourist attractions, this museum offers an intimate look into the community’s history, language, crafts, and spiritual practices. Visitors can see traditional musical instruments, sacred manuscripts, and artifacts that showcase the deep connection the Lepchas have with nature.
Kalimpong’s diverse cultural influences are reflected in its cuisine. The town is known for its authentic Tibetan and Nepali flavors, and no visit is complete without tasting Shaphalay (Tibetan bread stuffed with meat), Gundruk (fermented leafy greens), and Alu Dum (spicy potato dish). The town’s local bakeries are also a legacy of its colonial past, offering freshly baked muffins, tea cakes, and Kalimpong cheese, a rare delight found only here.
For those seeking a unique food experience, homestays in Kalimpong offer home-cooked local meals, where visitors can get a taste of authentic Lepcha, Bhutanese, and Tibetan cuisine. The warm hospitality of these family-run establishments makes the experience even more special.
While Darjeeling continues to be a classic hill station, Kalimpong provides an offbeat alternative for those looking to escape crowds and experience something different. Unlike Darjeeling, which is often bustling with tourists, Kalimpong offers secluded spots, a slower pace of life, and an intimate connection with nature. Additionally, Kalimpong is an excellent base for exploring the Neora Valley National Park, a haven for birdwatchers and wildlife enthusiasts This dense forest, home to the elusive Red Panda, is a great place for trekking and adventure seekers.
Kalimpong remains one of East India’s best-kept secrets. It offers the perfect balance between history, adventure, and tranquility, making it a dream destination for offbeat travelers. Whether you’re looking for peaceful monastery visits, thrilling hikes, colonial nostalgia, or cultural immersion, Kalimpong delivers in ways that most hill stations don’t.
As more travelers seek destinations that go beyond the usual tourist circuits, Kalimpong stands ready to enchant those willing to explore its hidden wonders. If you’re planning your next East India adventure, skip the overcrowded spots and let Kalimpong surprise you with its quiet charm and timeless beauty.

























